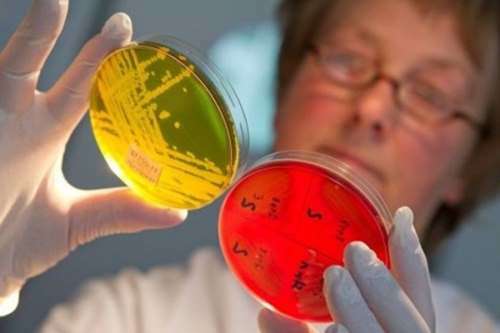

У Білій Церкві триває реконструкція стадіону на базі школи-інтернат в рамках “Великого будівництва”
У Білій Церкві продовжується реконструкція стадіону на базі місцевої школи-інтернат. Оновлення об’єкту проходить у рамках програми Президента України Володимира Зеленського “Велике будівництво”. kievvlast.com.ua »